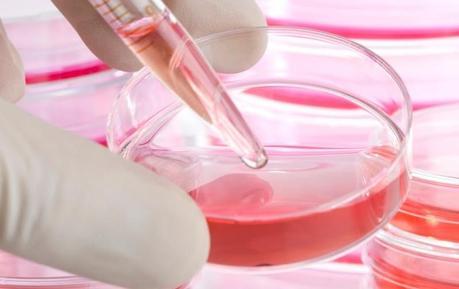
Tratamiento pionero con células de diseño

Enviado por Valeria RamirezHace apenas cinco meses Layla Richards, de tan solo un año, padecía de un tipo de leucemia agresiva incurable. Los médicos en Reino Unido no tenían nada más que ofrecer y como último recurso intentaron una terapia genética pionera, cuyos resultados han calificado de "casi milagrosos".
Enviado por Valeria RamirezHace apenas cinco meses Layla Richards, de tan solo un año, padecía de un tipo de leucemia agresiva incurable. Los médicos en Reino Unido no tenían nada más que ofrecer y como último recurso intentaron una terapia genética pionera, cuyos resultados han calificado de "casi milagrosos".Los especialistas utilizaron "células inmunes diseñadas" para combatir el cáncer de Layla. Es muy pronto para decir si está curada, pero los progresos que ha tenido ya significan -para los especialistas- un gran avance en la lucha contra el cáncer.
Layla fue diagnosticada con la enfermedad a los 3 meses de haber nacido en Londres. Como suele suceder en bebés tan pequeños, la quimioterapia y el trasplante de médula no pudieron curarla. Al no tener más opciones, el día antes del primer cumpleaños de la pequeña, los especialistas le dijeron a los padres que lo único que quedaba ahora era el cuidado paliativo.
 Pero el padre de Layla, Ashleigh, se negó a arrojar la toalla. "No quería ir por ese camino, prefería que trataran algo nuevo y me arriesgué. Y así está ella hoy en día riendo y en pie. Antes del tratamiento estaba tan débil... era horrible. Sencillamente estoy muy agradecido por esta oportunidad".
Pero el padre de Layla, Ashleigh, se negó a arrojar la toalla. "No quería ir por ese camino, prefería que trataran algo nuevo y me arriesgué. Y así está ella hoy en día riendo y en pie. Antes del tratamiento estaba tan débil... era horrible. Sencillamente estoy muy agradecido por esta oportunidad".Tijeras microscópicas
Para llegar a este momento, el personal médico, en conjunto con la empresa de biotecnología Cellectics, se apresuró a obtener todos los permisos necesarios para probar una terapia altamente experimental que sólo se había hecho en ratones.
El tratamiento, que consiste en diseñar células inmunes, es el resultado de los avances que se han hecho en edición de genes. Terapias anteriores habían intentado añadir genes nuevos para corregir un defecto, mientras que esta consistió en editar los genes que ya estaban ahí.
Para ello, en las células inmunes del donante se utilizaron unas tijeras microscópicas, conocidas como Talen. Estas células fueron diseñadas para hacerlas invisibles a los fuertes fármacos que se le suministra a los pacientes y para únicamente buscar y exterminar las células de la leucemia.
 Las células diseñadas fueron inyectadas en Layla. Además necesitó de un segundo trasplante de médula para restablecer su sistema inmune. Ahora, tan sólo meses después de que le dieran a su familia la devastadora noticia de que el cáncer era incurable, Layla no solo está viva, sino que no hay rastro de leucemia en su cuerpo.
Las células diseñadas fueron inyectadas en Layla. Además necesitó de un segundo trasplante de médula para restablecer su sistema inmune. Ahora, tan sólo meses después de que le dieran a su familia la devastadora noticia de que el cáncer era incurable, Layla no solo está viva, sino que no hay rastro de leucemia en su cuerpo."Casi como un milagro"
El doctor Paul Veys, del hospital Great Ormond Street de Londres, considera la transformación de Layla como una de las cosas más extraordinarias que haya visto en 20 años. "Estamos en una posición maravillosa, comparado a como estábamos hace cinco meses. Pero esto no significa que se haya curado", aclaró Veys. "La única forma de saber si se trata de una cura es esperar uno o dos años. Pero haber llegado hasta este punto es un paso muy, muy grande".
El especialista agrega que el caso es "casi como un milagro". La historia de Layla fue presentada en la Sociedad Americana de Hematología, pero este es solo un caso que no ha sido sometido a pruebas clínicas.
Sin embargo, expertos coinciden en que el ritmo del progreso en la tecnología de edición de genes es fenomenal. "Esta es la primera vez que células humanas, modificadas de esta forma, han sido administradas a un paciente, y este es un gran paso para nosotros", señaló el profesor Waseem Qasim del Great Ormond Street.
Sin embargo, expertos coinciden en que el ritmo del progreso en la tecnología de edición de genes es fenomenal. "Esta es la primera vez que células humanas, modificadas de esta forma, han sido administradas a un paciente, y este es un gran paso para nosotros", señaló el profesor Waseem Qasim del Great Ormond Street."La tecnología avanza muy rápido, de repente la habilidad de dirigirse a regiones muy específicas del genoma se ha hecho mucho más eficiente y creemos que esta tecnología estará en la siguiente fase de tratamientos", agregó.

